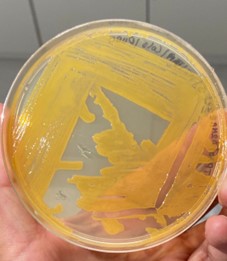
Análisis metagenómica, asignación taxonómica

FIG. | Aislado puro de muestras colectadas en la Reserva Madrigal
Esta investigación tiene como objetivo explorar la diversidad y composición de la comunidad microbiana del suelo y del intestino de escarabajos estercoleros en bosques montanos del sur del Ecuador, a lo largo de un gradiente paisajístico, específicamente en la Reserva Madrigal del Podocarpus, Loja-Ecuador. Esta reserva es conocida por su rica diversidad de flora y fauna; sin embargo, ha sufrido perturbaciones debido a actividades como la ganadería y los incendios forestales. Para este estudio, se seleccionaron tres tipos de cobertura vegetal: bosque natural, pastizal e incendio forestal. Se tomaron muestras tanto de suelo como del intestino de escarabajos estercoleros (Coleoptera: Scarabaeinae) de cada área. La investigación se centró en analizar la composición de las comunidades bacterianas mediante métodos de cultivo para aislar e identificar bacterias presentes en cada tipo de muestra. Se utilizaron pruebas bioquímicas, tinción Gram y la secuenciación masiva de la región V3 del gen ARNr 16S. Actualmente, se han preservado 200 aislados puros en congelación a -80°C. Mediante secuenciación multilocus, se han identificado más de 2000 géneros bacterianos en total. Los resultados preliminares indican que los géneros bacterianos predominantes en las muestras de suelo son Pseudomonas, Bacillus y Paenibacillus, mientras que en las muestras del intestino de los escarabajos los géneros dominantes son Escherichia y Acinetobacter. Estos géneros fueron obtenidos por ambas metodologías (cultivo y secuenciación masiva). El análisis de la riqueza y abundancia de estos géneros revela una compleja estructura de la comunidad bacteriana, con una alta diversidad y una distribución variada en función de los diferentes gradientes ambientales. En el suelo, las bacterias juegan roles clave en la descomposición de materia orgánica y la fijación de nutrientes. Por otro lado, las bacterias intestinales de los escarabajos podrían desempeñar funciones importantes en la digestión y potencialmente facilitar la dispersión de microorganismos beneficiosos. Particularmente relevante es el hallazgo de bacterias beneficiosas en el intestino de los escarabajos, lo cual sugiere que estos insectos pueden actuar como vehículos para la dispersión de dichas bacterias en nuevos hábitats. Los escarabajos, al moverse y alimentarse, introducen estas bacterias en el suelo, facilitando la colonización y mejorando la salud del mismo. Esta capacidad de actuar como vectores de bacterias beneficiosas abre nuevas posibilidades para el uso de escarabajos en estrategias de biocontrol y biofertilización, promoviendo ecosistemas más saludables y productivos.

FIG. | Análisis metagenómica, asignación taxonómica

FIG. | Abundancia de géneros bacterianos tanto en suelo como en el intestino de escarabajos, obtenidos mediante metagenómica

FIG. | Premio al mejor póster científico categoría Profesional - Universidad Central del Ecuador

